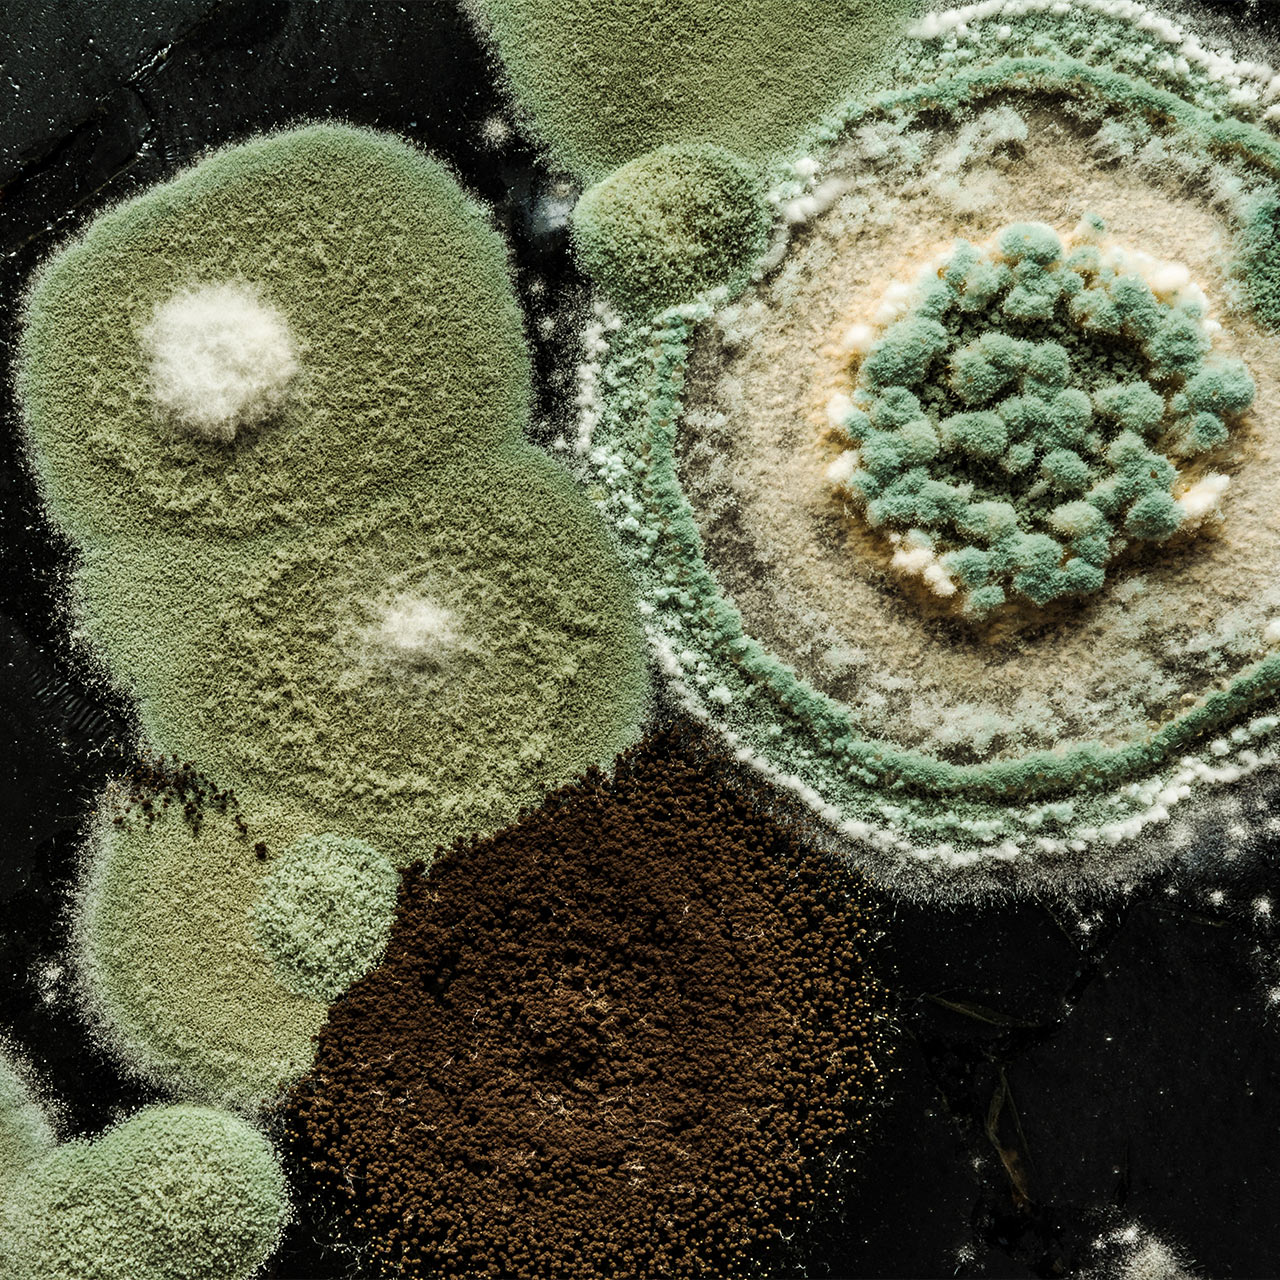

A
A
Una piastra: dove tutto ebbe inizio
La storia della penicillina è uno degli esempi più celebri di serendipità scientifica: una scoperta inattesa che ha rivoluzionato il mondo. Nel 1928, il batteriologo scozzese Alexander Fleming, mentre studiava le colture di Staphylococcus aureus nel suo laboratorio londinese, notò qualcosa di insolito. Una piastra di coltura era stata contaminata da una muffa, il Penicillium notatum, e intorno a quella colonia i batteri non crescevano.
Fleming, con lo sguardo allenato del ricercatore ma anche con la curiosità di chi sa cogliere l’imprevisto, comprese che la muffa stava producendo una sostanza capace di uccidere o bloccare i batteri. Quella sostanza prese il nome di penicillina. Tuttavia, trasformarla in un vero e proprio farmaco non fu immediato: furono necessari oltre dieci anni di lavoro, grazie anche ai contributi di Howard Florey, Ernst Chain e Norman Heatley, che misero a punto tecniche per produrre la penicillina su scala industriale.
Durante la Seconda guerra mondiale, questo antibiotico salvò migliaia di vite nei campi di battaglia, inaugurando l’era della terapia antibiotica. Fleming, Florey e Chain ricevettero il Premio Nobel per la Medicina nel 1945.
Un’innovazione senza precedenti nella storia dei farmaci
Prima della penicillina, le infezioni batteriche erano una delle principali cause di morte. Polmoniti, setticemie, ferite infette e malattie come la sifilide erano spesso letali, nonostante l’uso di antisettici o sieri poco efficaci. La penicillina inaugurò la stagione degli antibiotici moderni, i primi farmaci capaci non solo di alleviare i sintomi, ma di colpire direttamente i microrganismi responsabili della malattia.
Questo segnò una vera rivoluzione terapeutica: la medicina passò dall’arte del contenere e curare i sintomi all’abilità di eradicare le infezioni. La chimica farmaceutica, grazie alla struttura della penicillina, aprì la strada alla progettazione razionale di nuovi antibiotici, dando inizio a una corsa scientifica che avrebbe cambiato radicalmente le aspettative di vita dell’umanità.
La chimica della penicillina
La penicillina non è una singola molecola, ma una famiglia di antibiotici β-lattamici. Il loro nucleo chimico è un anello β-lattamico a quattro atomi fuso con un anello tiazolidinico: una struttura instabile e reattiva, fondamentale per l’attività antibatterica.
Il meccanismo d’azione è elegante: la penicillina si lega in modo irreversibile agli enzimi chiamati transpeptidasi, indispensabili per la sintesi della parete cellulare dei batteri.
Senza questa parete, le cellule batteriche non riescono a mantenere la loro integrità e finiscono per collassare.La possibilità di modificare chimicamente la struttura della penicillina ha permesso di ottenere derivati con caratteristiche diverse: maggiore resistenza agli acidi gastrici (come l’amoxicillina, che può essere assunta per via orale), o minore suscettibilità agli enzimi batterici che la inattivano (le penicillinasi). Questi sviluppi hanno reso la penicillina una pietra miliare della chimica farmaceutica.
Senza questa parete, le cellule batteriche non riescono a mantenere la loro integrità e finiscono per collassare.La possibilità di modificare chimicamente la struttura della penicillina ha permesso di ottenere derivati con caratteristiche diverse: maggiore resistenza agli acidi gastrici (come l’amoxicillina, che può essere assunta per via orale), o minore suscettibilità agli enzimi batterici che la inattivano (le penicillinasi). Questi sviluppi hanno reso la penicillina una pietra miliare della chimica farmaceutica.
Un lascito che continua a far riflettere
La storia della penicillina dimostra quanto la chimica sia intrecciata con la nostra vita quotidiana, spesso in modi che diamo per scontati. Oggi un’infezione curata con una compressa sembra banale e quasi scontato, ma solo un secolo fa poteva essere una condanna.
Quella piastra dimenticata nel laboratorio di Fleming non ci ha regalato soltanto un antibiotico: ci ha insegnato che il progresso nasce dall’incontro tra osservazione, curiosità e scienza applicata. È questo il contributo più grande che la chimica ha dato con la penicillina: aver trasformato il caso in conoscenza e la conoscenza in salute.